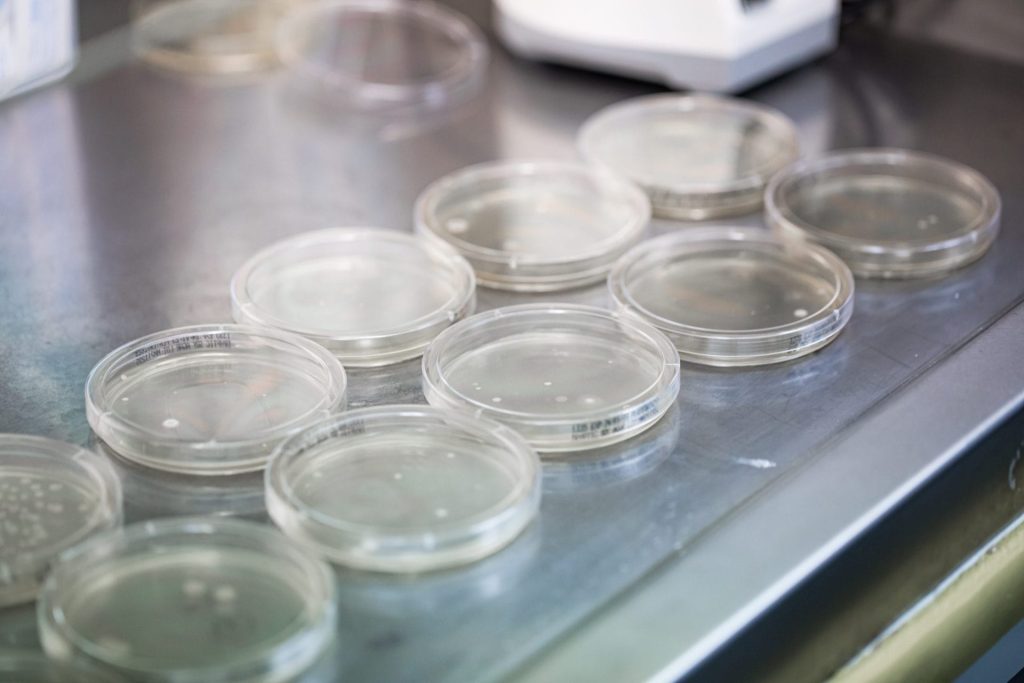
Air Testing for mould, yeast and bacteria

Mould, Yeast & Bacteria Air & Surface Testing – Operating Theatres & Food Manufacturing by Occupational Hygienists
Expert Sampling & Analysis by Occupational Hygienists for Enhanced Infection Control and Quality Control

Microbial Air & Surface Testing (Mould, Yeast & Bacteria) – Operating Theatres, Healthcare & Food Manufacturing Environments by Occupational Hygienists
Welcome to SESA, the leading provider of Safety & Environmental Services in Australia. We specialise in Mould, Yeast & Bacteria Air and Surface Testing, specifically tailored for operating theatres, healthcare and food manufacturing facilities. With our team of skilled Occupational Hygienists and our commitment to excellence, we ensure a clean and safe environment for both patients and healthcare professionals and food manufacturing work environment.
Read on to discover the benefits of choosing SESA for all your Mould, Yeast & Bacteria Air Testing needs.
Expert Occupational Hygienists: Ensuring Accurate Air Sampling, Surface Sampling & Analysis of Moud, Yeast & Bacteria
At SESA, we understand the critical importance of accurate and reliable Mould, Yeast & Bacteria Air Testing in operating theatres and healthcare settings. That’s why we have a team of expert Occupational Hygienists who possess extensive knowledge and experience in the field. Our hygienists are trained to conduct thorough assessments, employing industry-standard sampling methods and techniques. With their expertise, you can trust that the air quality in your healthcare facility will be assessed with precision and attention to detail.

Internal NATA accredited Laboratory: Quality and Efficiency
One of the key advantages of partnering with SESA for your Mould, Yeast & Bacteria Air Testing is our internal NATA accredited laboratory. Equipped with state-of-the-art technology and staffed by experienced professionals, our laboratory allows us to perform all necessary analyses efficiently and accurately. By eliminating the need for outsourcing, we maintain full control over the testing process, ensuring timely results without compromising on quality. This streamlined approach allows us to deliver comprehensive reports promptly with fast turnaround, giving you the information you need to ensure the health and safety of your patients and staff.
Specialised Microorganisms Air Testing and Surface Testing for Operating Theatres, Healthcare & Food Manufacturing Facilities
Operating theatres, healthcare food manufacturing environments require a specific focus on air quality and surface sterility due to the sensitive nature of patient care or cleanliness of the manufacturing facility. SESA specialises in Mould, Yeast & Bacteria Air Testing and Surface Testing that is specifically tailored for these settings and environments. Our Occupational Hygienists are equipped with the knowledge and understanding of the unique challenges and regulatory requirements of operating theatres, healthcare and food manufacturing facilities. By conducting thorough assessments, we help you identify potential sources of contamination and implement appropriate measures to maintain a clean and safe environment.
Would You Like to Know More
About Our Services
Call us today on 02 9822 8406, email us , or use our online enquiry form for further information about our services, to arrange an obligation-free
phone consultation or to discuss your requirements with us.

Pre-Commissioning of Operating Theatres (OT) Comprehensive Assessment of Airborne Mould, Yeast & Bacteria: Protecting Patients and Staff
The presence of mould, yeast, and bacteria in healthcare facilities can pose serious health risks to patients and healthcare professionals. SESA offers comprehensive Mould, Yeast & Bacteria Air Testing services to help you mitigate these risks effectively. Our Occupational Hygienists collect air samples using specialised equipment and techniques, ensuring a comprehensive assessment of the microbial environment. By identifying the types and levels of mould, yeast, and bacteria present, we provide you with valuable insights to develop targeted strategies for infection control and prevention.
SESA is experienced in undertaking air testing for operating suites prior to commissioning to verify the correct operation of the HVAC system in accordance with established standards.
The methods and guidelines applicable to the work include:
- AS/NZS3666.2:2011, Air Handling and water systems of building-Microbial Control, Part 2: Operation and Maintenance
- Australian Health Facility Guidelines (Appendix 1) Part D – Infection Prevention and Control D.0005 – Construction and Renovation
- In accordance with Procedures set down by Southern NSW LHD requirements (Appendix 2)
- Operational Directive: Microbiological Air Sampling of Operating Rooms in Western Australian Healthcare Facilities (OD: 0610/15; Issued June 2015) issued by Western Australia Department of Health
- Infection prevention and control during construction and renovation: toolkit (version 1.2; issued July 2018 by South Australia Health
- Moon, K. (2003). Infection Control Principles for the Management of Construction, Renovation, Repairs and Maintenance within Health Care Facilities. Loddon Mallee Region Infection Control Resource Centre, Bendigo. 2
- Hoffman, P. N., Williams, J., Stacey, A., et al. (2002). Microbiological commissioning and monitoring of operating theatre suites. Journal of Hospital Infection 52: 1-28. 3
- Department of Health Estates and Facilities Division. (2007). Health Technical Memorandum (HTM) 03-01: Specialised ventilation for healthcare premises. Part A – design and validation. London: The Stationery Office, United Kingdom
Compliance with Industry Standards and Regulations: Ensuring Patient Safety & Clean Conditions
Maintaining compliance with industry standards and regulations is crucial in the healthcare sector and food manufacturing environments. SESA’s Mould, Yeast & Bacteria Air Testing and Surface Testing services are designed to help you meet these requirements. Our Occupational Hygienists are well-versed in the guidelines and standards set forth by regulatory bodies. We conduct our testing in accordance with these standards, ensuring that your facility meets the necessary criteria for patient safety and infection control and/or surface cleanliness and non-contamination. With SESA as your partner, you can have confidence in the cleanliness and safety of your operating theatres, healthcare and other critical environments.
The microorganisms sampling will include sampling airborne bacteria, mould and yeast in the operating theatre and if required in adjacent rooms (eg. sterile stock room). Duplicate samples will be collected for airborne bacteria and duplicate samples will be collected for mould and yeast in each room. The average of the two duplicates will be used for comparison with the guidelines.
Prior to testing the following requirements must be met:
- The rooms shall be empty of all non-fixed items, including supplies, sterile stock and any mobile equipment.
- No microbiological air sampling shall be conducted until:
- all building and construction works have been completed
- all HVAC commissioning procedures have been completed
- all the ducting and air diffuser plates have been cleaned
- the room being sampled has been thoroughly cleaned, including ceiling spaces, service cavities, ventilation grills, all horizontal and vertical
- surfaces including ceilings and walls, and any fixed equipment in the room
- a second clean of all horizontal and vertical surfaces within the room is recommended to ensure any contamination is removed
- the HVAC system has been running continuously, on normal flow rates, for at least 24 hours following completion of all building and construction. Cleaning can be performed during this period of time
- No construction workers or non-sterile materials to enter the room after the cleaning
The samples will be aseptically handled as required and transported under a chain of custody to NATA accredited laboratory for analysis in accordance with their NATA accredited method which involves an incubation period of 3 days for bacteria samples and 5 days for fungi (mould and yeast) samples.
OD: 0610/15 states that “Aerobic cultures on non-selective media should not exceed 10 bacterial and or fungal CFUs per cubic metre (m3) of air sampled”. This criterion will be used to evaluate the analytical results of the aerobic culture samples.

Clear and Detailed Reporting: Transparent Communication
Transparency is at the core of our services at SESA. After completing the Mould, Yeast & Bacteria Air Testing, our Occupational Hygienists compile detailed reports that clearly outline the findings and recommendations. These reports provide you with a comprehensive understanding of the microbial environment in your healthcare facility, allowing you to make informed decisions regarding infection control measures. Our clear and detailed reporting ensures transparent communication, empowering you to take the necessary steps to protect the health and well-being of your patients and staff.
Choose SESA for Reliable Mould, Yeast & Bacteria Air Testing
When it comes to Mould, Yeast & Bacteria Air Testing in operating theatres and healthcare facilities, SESA is your trusted partner in Australia. With our team of expert Occupational Hygienists, internal fully certified laboratory, specialised testing services, compliance with industry standards, and transparent reporting, we ensure the highest quality assessment for the safety and well-being of your patients and staff. Contact us today to learn more about our services or to schedule a consultation. Together, let’s create a healthier and safer environment for everyone in your healthcare facility.
- Occupational Hygiene Services
- Indoor Air Quality Testing
- Dust Air Monitoring
- Silica Dust Air Monitoring
- Workplace Noise Surveys & Assessment
- Workplace Audiometric Testing
- Mould Inspection, Testing & Assessment
- Mould Testing | NATA Accredited Laboratory
- Mould Post Remediation Verification Testing
- Mould, Yeast & Bacteria Air Testing
- Cleanroom Air Testing
- Meth Residues Testing
- Mould Hygienist
- Asbestos Hygienist
- Occupational Hygienist Expert Reports


- Contact Us
Get A Quote

- Contact Us
